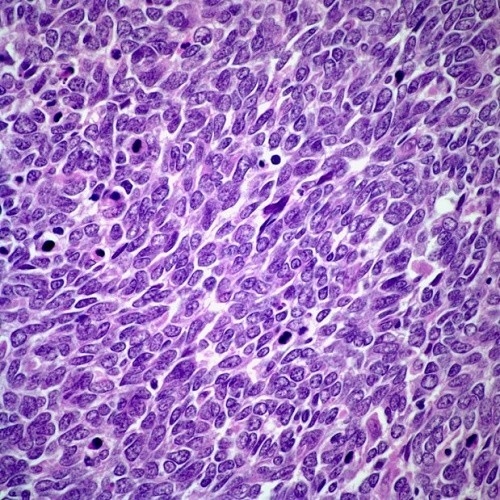

Ung thư phổi tế bào nhỏ – loại ung thư phổi hiếm gặp
1. Ung thư phổi tế bào nhỏ là gì?
Ung thư phổi chia thành 2 loại: ung thư phổi không tế bào nhỏ và ung thư phổi tế bào nhỏ. Trong đó, ung thư phổi tế bào nhỏ chiếm 15% – 16% các trường hợp ung thư phổi và là loại ung thư phổi nguy hiểm nhất. Đây là loại ung thư phổi phát triển nhanh chóng, nó có thể di căn tới rất nhiều bộ phận khác trên cơ thể nên rất khó có thể loại bỏ triệt để các khối u bằng phương pháp phẫu thuật. Tuy nhiên, ung thư phổi tế bào nhỏ thường đáp ứng tốt với hóa trị liệu ban đầu. Tuy nhiên, nó có xu hướng tái phát sau điều trị ban đầu và có khả năng kháng điều trị nhiều hơn trong lần hóa trị liệu tiếp theo.
Ung thư phổi tế bào nhỏ chiếm 15% – 16% các trường hợp ung thư phổi
Ung thư phổi tế bào nhỏ thường bắt đầu trong đường hô hấp lớn (phế quản) phổi, nhưng lây lan sớm, thường lan đến não. Ung thư phổi tế bào nhỏ thường chia làm 2 giai đoạn: giai đoạn hạn chế và mở rộng.
2. Nguyên nhân ung thư phổi tế bào nhỏ?
Ung thư phổi tế bào nhỏ nguyên nhân chủ yếu là do hút thuốc, mặc dù các yếu tố khác cũng có liên quan như tiếp xúc với khí radon và amiăng cũng có liên quan. Đây là loại ung thư phổi phổ biến hơn ở nam giới.
3. Các triệu chứng của ung thư phổi tế bào nhỏ
Các dấu hiệu của ung thư phổi tế bào nhỏ bao gồm:
- Sưng ở mặt và cổ
- Khó thở, thở khò khè
- Ho dai dẳng
- Ho ra máu
- Nhiễm trùng thường xuyên
- Khàn tiếng
- Mệt mỏi
- Giảm cân không rõ nguyên nhân
Ho, khó thở kéo dài cảnh báo ung thư phổi
Các triệu chứng khi khối u lây lan sang các khu vực khác của cơ thể bao gồm: đau ở lưng, hông, hoặc xương sườn (ung thư lan tới xương); nhức đầu, thay đổi thị lực, suy nhược, hoặc động kinh (di căn tới não)…
4. Điều trị ung thư phổi tế bào nhỏ
Tùy từng trường hợp mà bác sĩ sẽ chỉ định phác đồ điều trị cụ thể. Phẫu thuật hiếm khi được thực hiện đối với ung thư phổi tế bào nhỏ, nhưng đôi khi bác sĩ có thể xem xét nếu một hạch nhỏ được tìm thấy khi chụp X-quang hoặc chụp CT. Hóa trị thường được sử dụng (sau phẫu thuật) nếu phẫu thuật có thể thực hiện đối với ung thư phổi tế bào nhỏ. Trong hầu hết các trường hợp, điều trị bệnh giai đoạn tiến triển bao gồm trong hóa trị liệu được sử dụng một mình.
5. Tiên lượng ung thư phổi tế bào nhỏ
Tỷ lệ sống 5 năm trung bình là 31% cho giai đoạn 1, 19% cho giai đoạn 2, 8% cho giai đoạn 3, và 2% cho giai đoạn 4.
Tùy từng trường hợp mà bác sĩ sẽ chỉ định phác đồ điều trị cụ thể
Tùy vào tình trạng sức khỏe tại thời điểm chẩn đoán, tuổi tác, giới tính, giai đoạn bệnh… mà tiên lượng của từng bệnh nhân sẽ khác nhau.
Tại Bệnh viện Thu Cúc, bệnh nhân ung thư phổi tế bào nhỏ có cơ hội được điều trị với TS.BS Lim Hong Liang – bác sĩ điều trị ung thư giỏi từ Singapore, đang hợp tác điều trị tại đây.